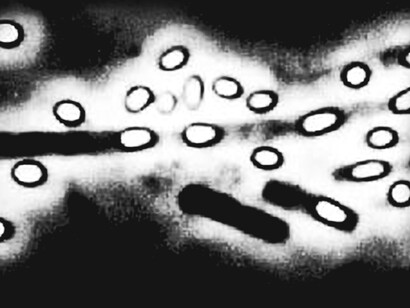
Maladie du charbon. Le bacille du charbon a la faculté de former des spores résistantes à divers traitements

La deuxième moitié du XIXe siècle consacre l’existence et le rôle des microbes, plus noblement appelés microorganismes. Ils sont partout ou presque, et l’on met en évidence leurs effets tantôt bénéfiques où ils sont responsables de processus utiles, comme des fermentations mais aussi de certains mécanismes physiologiques, tantôt pathogènes pour l’être humain comme pour les animaux. Or si la découverte des causes – microbiennes – de certaines maladies a permis de limiter les risques de contamination par des mesures d’hygiène mieux maitrisées, force est de constater qu’on ne sait pas – pas encore – les éliminer. Et pourtant, depuis des siècles et en divers lieux l’humanité a mis au point, de façon totalement empirique, une étrange méthode pour se prémunir de certaines maladies. Comment Pasteur entre-t-il en scène ? Quels ont été ses apports singuliers et comment s’est-il appuyé sur ce « déjà-là » pour mettre au point ses premiers vaccins ?
Ayant étudié la maladie du charbon qui décimait le bétail dans certaines régions du pays, Pasteur, qui en avait identifié le bacille responsable à peu près au même moment que son collègue et concurrent allemand Koch, était de plus en plus convaincu qu’il serait possible de protéger les animaux par un procédé de vaccination inspiré plus ou moins du célèbre médecin anglais du XVIIIe siècle, Jenner. On lira avec intérêt Maladie du charbon, un bacille joue à cache-cache ; Maladie du charbon, Pasteur achève la démonstration microbienne ; De Jenner à Pasteur ; Un pari osé, vacciner contre la maladie du charbon.
Instruit de l’expérience du choléra des poules, Pasteur n’a de cesse que de chercher à la transférer à d’autres maladies. Il dispose de cette idée princeps de l’atténuation : quel que soit le procédé de son obtention, la souche non virulente confère l’immunité. Le problème devient double : comment parvenir à atténuer le microbe de façon régulière ? Quels sont l’origine et le mécanisme de cette protection acquise ? Au fond, qu’est-ce qu’un vaccin ?
La mystérieuse recette
Le vieillissement d’une culture microbienne, joint au courant d’oxygène qui avait été appliquée par Roux dans le cas du choléra des poules, sont-ils des moyens universels d’obtenir une préparation vaccinale, applicable à diverses maladies infectieuses ? Pasteur est dubitatif sur le courant d’oxygène, puisque des bactéries aérobies strictes sont curieusement atténuées par l’oxygène. Mais faute de mieux pour le moment, il le pratique.
A l’opposé de cet affaiblissement voire disparition de la virulence du germe par ce traitement, Pasteur et Koch avaient montré, chacun de leur côté, que des contaminations successives d’animal à animal la font réapparaitre, voire la renforcent. Encore plus fort, Pasteur obtient la réversibilité, le retour à la virulence, par inoculations successives : à des animaux nouveau-nés pour le charbon ; à des oisillons pour le choléra des poules. La virulence est graduée et graduable. Plus intriguant encore, Pasteur constate qu’à force de repiquer une culture bactérienne, la virulence peut également s’atténuer, à condition que le délai entre deux repiquages augmente.
C’était à n’y plus rien comprendre. Ces faits pouvaient être rapprochés de pratiques ancestrales des éleveurs. On savait par exemple que dans la péripneumonie des bovins, inoculer du liquide pulmonaire dans la queue d’un animal sain le protégeait. On pensait alors que la distance (entre queue et poumons) pouvait jouer un rôle dans cette immunisation, soit que le corps avait le temps de se défendre, soit que la maladie s’affaiblissait au cours du trajet. Par ailleurs, on savait très bien dans les campagnes que des moutons résistent à la maladie du charbon, même dans un milieu fortement contaminant. Cette immunité qui paraît naturelle est-elle innée, ou a-t-elle été acquise par suite de la contraction d’une forme bénigne ou passée inaperçue de la maladie, un peu comme dans le cas de variole ?
En août 1880, un professeur de physiologie à l’École vétérinaire de Toulouse annonce qu’il a réussi à vacciner contre le charbon. Pasteur est-il doublé ? Il connait Jean-Joseph Henry Toussaint. Ils s’étaient attelés tous deux, mais séparément, en Beauce, à des observations sur le charbon. Admiratif, Pasteur est néanmoins troublé, pour ne pas dire jaloux. Depuis Arbois il expédie des instructions à Chamberland pour reproduire les essais de Toussaint, avec du vaccin que ce dernier fait parvenir à Paris depuis Toulouse. Pasteur est furieux : il semble qu’au cours du voyage, le vaccin soit redevenu du microbe actif non atténué. Or quelle a été la méthode de Toussaint ? La question de la technique de préparation du vaccin rencontre de fait celle de la nature exacte et du mode d’action de la vaccination. C’est souvent le cas en science : pour convaincre aussi bien que pour faire avancer des recherches, les données empiriques doivent s’articuler à des explications théoriques.
Du bricolage empirique au bricolage théorique
La conviction de Pasteur selon laquelle c’est bien un germe atténué qui confère l’immunité restera forte chez lui. Ses préparations vaccinales contiennent des microbes vivants, quoique non virulents. Pour Toussaint au contraire, ce n’est pas si sûr. Le vétérinaire prétend avoir vacciné des animaux avec du sang charbonneux préalablement filtré, pour en éliminer tous les éléments figurés : cellules sanguines aussi bien que bacilles charbonneux. Il en déduit, suivant du reste l’opinion d’un de ses collègues, que le vaccin est une substance soluble (dans le plasma sanguin) produite très certainement par le bacille et qui aurait cette propriété immunisante. Attention, l’excrétion supposée de cette substance par le bacille ceci est sans rapport avec celle des toxines microbiennes qui seront découvertes plus tard (cas de la diphtérie), et qui au contraire ont un effet pathogène.
Pourtant, invité à refaire ses expériences à l’école vétérinaire de Maisons-Alfort près de Paris, Toussaint ne parvient pas à reproduire ses premiers résultats. Il adopte alors une autre technique : chauffer le sang contaminé à 55° pendant 10 minutes, ce qui devrait tuer les bacilles, sans altérer le supposé corps soluble excrété par le bacille. Car Toussaint reste persuadé que le vaccin n’est pas un germe vivant. Nouvel échec. Il change encore de technique : il traite des échantillons de sang charbonneux avec un antiseptique, l’acide glycolique, qui agit de façon comparable au phénol prôné par l’anglais Joseph Lister (1827-1912), père de l’antisepsie. Cette fois, il réussit sa vaccination animale. Pasteur est à nouveau troublé et il demande à Roux et Chamberland de tester les protocoles de Toussaint. C’est eux qui s’aperçoivent que les antiseptiques, l’acide glycolique employé par Toussaint ainsi que d’autres produits, transforment la culture virulente en culture non virulente.
Dans cette affaire, le vétérinaire a réussi à mettre au point un vaccin, mais avec une théorie fausse, puisqu’il pense que l’antiseptique a détruit le microbe et pas la substance soluble que celui-ci aurait produite avant de mourir. La thèse de Pasteur était-elle plus solide ?
Avant d’examiner ce point, il importe de préciser ce qu’il s’était passé lors du transport du vaccin préparé par Toussaint à Toulouse et qui, arrivé à Paris, était constitué de microbe actif, virulent. Il est vrai que la filtration du sang opérée par Toussaint ne l’avait pas débarrassé de tous les bacilles de l’anthrax. À preuve, l’échec de Toussaint lorsqu’il chauffe cette fois le sang contaminé à 55° ; les microbes ayant été tués, aucune vaccination n’a pu être obtenue et les bêtes vaccinées par ce procédé étaient aussitôt malades dès leur mise en contact avec du charbon bien actif. En effet, le bacille du charbon a la faculté de former des spores résistantes à divers traitements. Aussi, avant que l’atténuation ne puisse intervenir, les bacilles sporulent, et la préparation inoculée, au lieu de vacciner, provoque au contraire la maladie, car les spores se réactivent au contact de leur animal hôte.
Pour sa part, Pasteur, qui reste sur sa conviction que le vaccin est bien un virus vivant, explique le phénomène d’immunisation d’une tout autre façon que Toussaint. De longue date, dès l’étude des fermentations, Pasteur observe que la nourriture est le facteur limitant de la prolifération microbienne. S’il y a bien deux types de bacilles, l’un virulent l’autre non virulent mais tous deux bien vivants, voici ce qu’il se passe, selon lui, quand on vaccine l’animal avec la forme atténuée. Celle-ci, en se développant au sein de l’organisme, épuise la ressource nutritive, empêchant la forme virulente, si elle attaque l’animal, de se développer faute de substances nutritives déjà consommées par la forme atténuée. Vue d’aujourd’hui, cette explication par la compétition pour la nourriture peut paraitre fantaisiste. Elle était toutefois nécessaire à Pasteur pour asseoir sa méthode de fabrication du vaccin, et conforme à ce qu’il avait appris de l’étude des microbes.
Epilogue : la stabilisation du vaccin
L’équipe de Pasteur est donc confortée après l’épisode Toussaint, car si ce dernier a réussi à vacciner efficacement, il a été déconsidéré par ses premiers échecs, et c’est, une fois de plus, Pasteur qui triomphe. Pour autant, la mise au point n’est pas terminée : il faut produire un vaccin stable et durablement efficace. L’idée du chauffage fait son chemin, mais l’équipe pastorienne observe qu’un chauffage bref inactive le bacille sans pour autant empêcher la sporulation.
A force d’essais, Pasteur obtient, six mois plus tard, un vaccin efficace et stable. Il est alors prêt pour affronter l’arène publique – le défi de Pouilly-le-Fort –, tandis qu’il a frôlé la catastrophe. Car dans son laboratoire, les résultats qu’il obtenait n’étaient pas constants. La recette finale consiste à cultiver le bacille à 42-43°C pendant huit jours, tout en oxygénant les cultures, et en appliquant le traitement au phénol. Dans ces conditions, les spores ne se forment pas et la virulence diminue.
Il communique ses résultats en mars 1881 :
Chercher à amoindrir la virulence par des moyens rationnels, c’est fonder sur l’expérimentation l’espoir de préparer, avec des virus actifs, de facile culture dans le corps de l’homme ou des animaux, des virus-vaccins de développement restreint, capables de prévenir les effets mortels des premiers.
(Cité par Debré, 1995, p. 416)
Pasteur est sûr de lui au point de proposer à Gambetta que soit créé un établissement de production de vaccins, sans succès à ce moment.
Le vaccin est donc bien dans tous les cas un microbe atténué, mais la question de l’atténuation demeure une réelle énigme.
Sources
Patrice Debré, Louis Pasteur, Champs biographie, 1995.
Michel Morange, Pasteur, Gallimard, 2022.